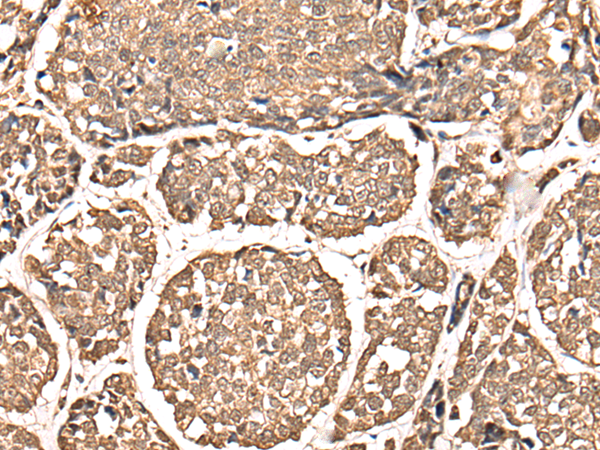

-
分类: 科研抗体货号: P00419别名: H1C; H1.2; H1F2; H1s-1; HIST1H1C应用: IHC反应种属: Human
-
分类: 科研抗体货号: P00369别名: GIG3, MORT1应用: WB,IHC反应种属: Human, Mouse
-
分类: 科研抗体货号: P00416别名: JTK9; p59Hck; p61Hck应用: WB,IHC反应种属: Human, Mouse, Rat
-
分类: 科研抗体货号: P00440别名: DFF1; ICAD; DFF-45应用: WB,IHC反应种属: Human
-
分类: 科研抗体货号: P00439别名: IBA1, IRT1, AIF-1, IRT-1应用: WB,IHC反应种属: Human, Mouse, Rat
-
分类: 科研抗体货号: P00415别名: HAI, HAI1, MANSC2应用: IHC反应种属: Human, Mouse
-
分类: 科研抗体货号: P00435别名: H11; HMN2; CMT2L; DHMN2; E2IG1; HMN2A; HSP22应用: IHC反应种属: Human, Mouse, Rat
-
分类: 科研抗体货号: P00414别名: ERG2; ERG-2; HERG2; Kv11.2; hERG-2应用: WB,IHC反应种属: Human, Rat
-
分类: 科研抗体货号: P00429别名: BP, HPA1S, HP2ALPHA2应用: IHC反应种属: Human, Mouse, Rat
-
分类: 科研抗体货号: P00474别名: IPD1; REN64; IRAK-4; NY-REN-64应用: IHC反应种属: Human, Mouse

鄂公网安备42018502007531号
鄂公网安备42018502007531号

